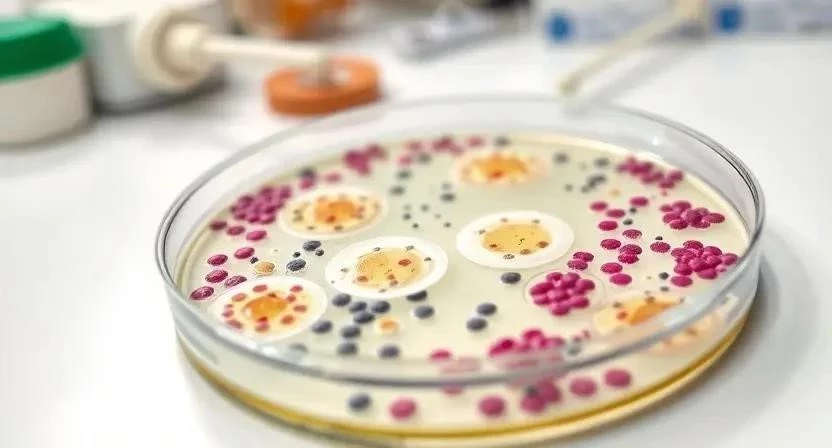

Замечали ли вы, как быстро дети приносят домой новые микробы? Кашель, насморк, боль в горле – знакомая картина для многих родителей. Но как понять, что это обычная простуда, а не бактериальная инфекция, требующая серьезного лечения? По статистике, бактериальные инфекции составляют значительную часть всех детских заболеваний. Важно вовремя распознать симптомы и обратиться к врачу, чтобы избежать осложнений. В этой статье мы подробно разберем, что такое бактериальные инфекции у детей, как их диагностировать, лечить и предотвращать.
Бактериальные инфекции – это заболевания, вызванные размножением бактерий в организме ребенка. Они отличаются от вирусных инфекций, которые вызываются вирусами. Бактерии – это одноклеточные микроорганизмы, некоторые из которых полезны для нашего организма, а другие – патогенны, то есть вызывают болезни. Наиболее распространенные типы бактерий, вызывающих инфекции у детей, включают стрептококки, стафилококки и кишечную палочку. Важно понимать, что не все бактерии вредны, и антибиотики эффективны только против бактериальных инфекций, а не против вирусных.
- Симптомы бактериальных инфекций у детей
- Наиболее распространенные бактериальные инфекции у детей
- Диагностика бактериальных инфекций
- Лечение бактериальных инфекций у детей
- Профилактика бактериальных инфекций
- Осложнения бактериальных инфекций
- FAQ
- Таблица 1: Симптомы различных бактериальных инфекций
- Таблица 2: Антибиотики для детей: дозировки и особенности применения
- Таблица 3: Профилактические меры
Симптомы бактериальных инфекций у детей
Симптомы бактериальных инфекций могут варьироваться в зависимости от типа инфекции и возраста ребенка. Однако, есть общие признаки, на которые стоит обратить внимание. К ним относятся высокая температура (выше 38°C), которая плохо сбивается жаропонижающими средствами, сильный кашель с гнойной мокротой, обильный насморк с густыми выделениями, боль в горле при глотании, сыпь на коже, рвота и диарея. Важно помнить, что эти симптомы могут быть похожи на симптомы вирусных инфекций, поэтому для точной диагностики необходимо обратиться к врачу.
Наиболее распространенные бактериальные инфекции у детей
- Бактериальный бронхит: характеризуется сильным кашлем, высокой температурой и затрудненным дыханием.
- Ангина (стрептококковая): проявляется болью в горле, высокой температурой, увеличенными и болезненными лимфоузлами на шее.
- Отит: вызывает боль в ухе, высокую температуру и раздражительность у ребенка.
- Инфекции мочевыводящих путей: проявляются болью при мочеиспускании, частыми позывами к мочеиспусканию и высокой температурой.
- Лишай (особенности у детей): характеризуется появлением зудящих, красных пятен на коже.
- Менингит (кратко): серьезное заболевание, вызывающее воспаление оболочек головного и спинного мозга, проявляется высокой температурой, головной болью, рвотой и ригидностью затылочных мышц.
Недавно у моего племянника был бактериальный бронхит. Я помню, как тяжело ему было дышать, и как быстро поднялась температура. Родители сразу обратились к врачу, и ему назначили антибиотики. Уже через несколько дней ему стало лучше, и он снова начал играть.

Диагностика бактериальных инфекций
Для точной диагностики бактериальной инфекции необходимо обратиться к педиатру. Врач проведет осмотр ребенка, соберет анамнез и назначит необходимые анализы. К основным анализам относятся общий анализ крови, который позволяет оценить уровень лейкоцитов и других показателей, свидетельствующих о воспалении, бактериологический посев, который позволяет определить тип бактерии, вызвавшей инфекцию, и ПЦР-диагностика, которая позволяет быстро и точно выявить наличие бактериальной ДНК в организме. Важно помнить, что самолечение может быть опасным и привести к осложнениям.
Лечение бактериальных инфекций у детей
- Антибиотикотерапия: является основным методом лечения бактериальных инфекций. Выбор препарата, дозировка и длительность курса лечения должны определяться врачом, исходя из типа инфекции, возраста ребенка и его общего состояния.
- Симптоматическое лечение: включает жаропонижающие средства для снижения температуры, обезболивающие средства для облегчения боли и обильное питье для предотвращения обезвоживания.
- Госпитализация: может потребоваться в тяжелых случаях, когда состояние ребенка ухудшается, или когда необходимо проводить внутривенное введение антибиотиков.
Однажды моя дочь заболела ангиной. Врач назначил ей антибиотики, и я строго следила за тем, чтобы она принимала их вовремя и в правильной дозировке. Кроме того, я давала ей много теплого питья и следила за тем, чтобы она хорошо отдыхала. Через несколько дней ей стало лучше, и она снова пошла в детский сад.
Профилактика бактериальных инфекций
- Гигиена: регулярное мытье рук с мылом, проветривание помещений и влажная уборка помогают снизить риск распространения бактерий.
- Вакцинация: вакцинация против некоторых бактериальных инфекций, таких как пневмококковая инфекция и гемофильная инфекция типа b, помогает защитить ребенка от этих заболеваний.
- Укрепление иммунитета: здоровый образ жизни, правильное питание и достаточный сон помогают укрепить иммунитет ребенка и повысить его устойчивость к инфекциям.
- Правильное питание: сбалансированное питание, богатое витаминами и минералами, помогает укрепить иммунитет ребенка.

Осложнения бактериальных инфекций
Бактериальные инфекции могут привести к серьезным осложнениям, таким как пневмония, менингит, сепсис и ревматизм. Чтобы предотвратить осложнения, важно своевременно обращаться к врачу и строго следовать его рекомендациям по лечению. Важно также соблюдать профилактические меры, такие как гигиена и вакцинация.
Я помню, как моя подруга не обратила внимания на симптомы бактериального бронхита у своего сына. В результате у него развилась пневмония, и ему пришлось долго лечиться в больнице. Этот случай научил меня тому, что нельзя игнорировать симптомы инфекций у детей.
FAQ
Вопрос: Что делать, если у ребенка высокая температура?
Ответ: Если у ребенка высокая температура (выше 38°C), необходимо дать ему жаропонижающее средство и обратиться к врачу.
Вопрос: Когда нужно обращаться к врачу?
Ответ: Обращаться к врачу необходимо при появлении любых симптомов бактериальной инфекции, таких как высокая температура, кашель, насморк, боль в горле, сыпь, рвота и диарея.
Вопрос: Можно ли лечить бактериальную инфекцию дома?
Ответ: Лечение бактериальной инфекции должно проводиться под контролем врача. Самолечение может быть опасным и привести к осложнениям.
Вопрос: Как укрепить иммунитет ребенка?
Ответ: Укрепить иммунитет ребенка можно с помощью здорового образа жизни, правильного питания, достаточного сна и вакцинации.
Таблица 1: Симптомы различных бактериальных инфекций
| Инфекция | Симптомы |
|—|—|
| Бактериальный бронхит | Кашель, высокая температура, затрудненное дыхание |
| Ангина (стрептококковая) | Боль в горле, высокая температура, увеличенные лимфоузлы |
| Отит | Боль в ухе, высокая температура, раздражительность |
| Инфекции мочевыводящих путей | Боль при мочеиспускании, частые позывы к мочеиспусканию, высокая температура |
| Лишай | Зуд, красные пятна на коже |
Таблица 2: Антибиотики для детей: дозировки и особенности применения
| Антибиотик | Дозировка | Особенности применения |
|—|—|—|
| Амоксициллин | Зависит от веса ребенка | Принимать во время еды |
| Цефалексин | Зависит от веса ребенка | Принимать во время еды |
| Азитромицин | Зависит от веса ребенка | Принимать один раз в день |
Таблица 3: Профилактические меры
| Мера | Описание |
|—|—|
| Мытье рук | Регулярное мытье рук с мылом |
| Вакцинация | Вакцинация против бактериальных инфекций |
| Проветривание | Регулярное проветривание помещений |
| Правильное питание | Сбалансированное питание, богатое витаминами и минералами |